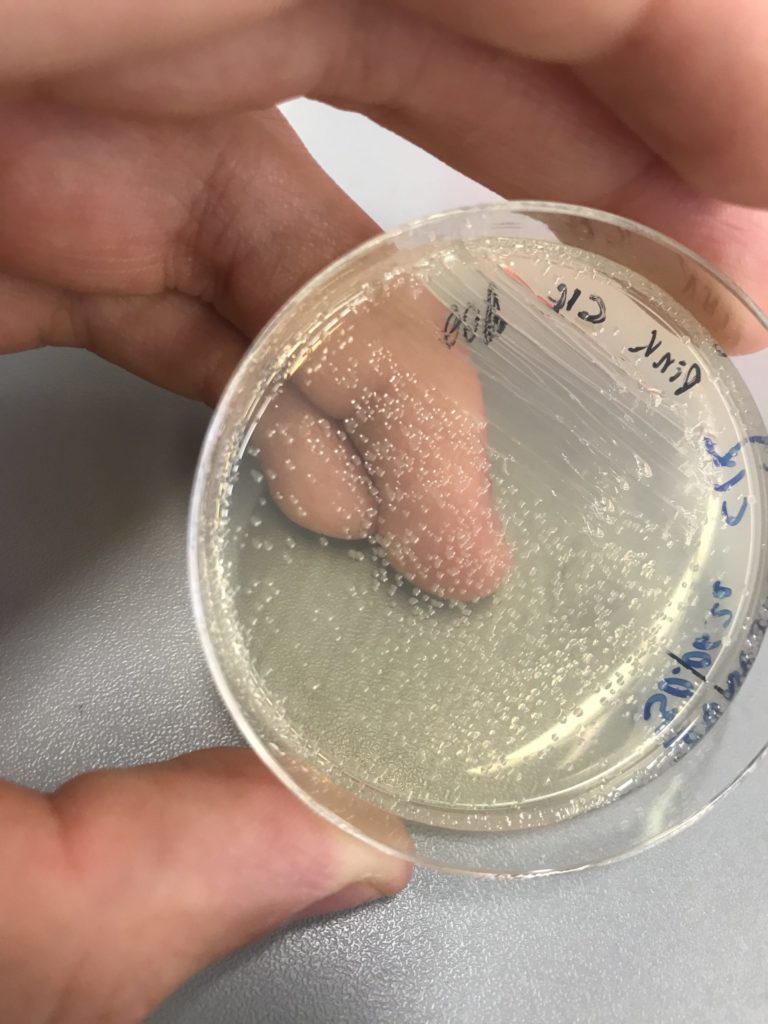

Projektwoche 09.-13.08.2021
Was ist eigentlich CRISPR/Cas? Eine neue Kekssorte oder vielleicht ein exotisches Gericht? Eine solche oder ähnliche Frage stellen sich wohl viele, wenn sie von dieser Methode zum ersten Mal hören. Doch CRISPR/Cas ist lediglich eine Abkürzung für Clustered Regularly Interspaced Short Palindromic Repeats. Und es bezeichnet ein Verfahren der Molekularbiologe, durch das man DNA gezielt schneiden und verändern kann.
Doch warum erkläre ich hier ein solches Verfahren? Ganz einfach, mit genau dieser Art der Genomeditierung beschäftigte ich mich eine Woche lang im Gläsernen Labor, auf dem Campus Berlin Buch. In dem vom 28. Juni bis zum 2. Juli dauernden Schülerpraktikum erhielt ich und neun weitere interessierte Schülerinnen und Schüler eine Einführung in selbige und die Möglichkeit CRISPR/Cas an einer Beispielkultur selbst durchzuführen. Hierbei hatten wir ein breit gefächertes Aufgabenfeld, welches vom Ansetzten unserer eigene E.coli-Kulturen bis zum Crispern an eben diesen reichte.
Das Ziel der Woche war es, die durch einen bestimmten Farbstoff blau gefärbten E. coli-Kulturen durch die CRISPR/Cas-Methode in ihren ursprünglich weißen Zustand zu versetzten. Dies gelang, durch das Abtrennen des lacZ-Gens, wodurch die ß-Galactosidase nicht länger produziert und die Farbstoffvorstufe X-Gal nicht länger gespalten und zu dem blauen Farbstoff verarbeitet werden konnte.
Diese Woche, war abgesehen vom Montag, welcher der Einführungstag war, mit 6 verschieden Experimenten vollgepackt. Diese unterschiedlichen Versuche reichten vom Anlegen von E. coli-Kulturen bis hin zu dem Präparieren von Zellen und Enzymen. Jedoch dienten alle diese unterschiedlichen Arbeitsschritte dazu, ein Ziel hinzu erreichen, nämlich Darmbakterien zu crispern. Wie schon erwähnt, sollte durch das Anwenden von CRISPR/Cas einst blaue Bakterien weiß werden. Dies könnte man zwar mit dem bloßen Auge bestätigen, es gab jedoch eine weitere Verifikationsmethode, die wir anwandten, um einen Irrtum auszuschließen.
Die erste war eine rein optische und somit eher unwissenschaftliche; zwei E. coli-Kolonien wurden jeweils einmal mit und ohne CRISPR-Plasmid gezüchtet. Durch das CRISPR/Cas 9-Plasmid kommt es zum Doppelstrangbruch im lacZ-Gen, weshalb die ß-Galactosidase nicht länger produziert und der Farbstoff nicht länger gebildet werden kann und die Zellen alsso in Weiß erstrahlen. Dieser Versuch ließ sich mit eigenen Augen sowie unter UV-Licht bestätigen.
Der zweite Ansatz war etwas komplizierte. Unter dem Cracking-Gel, versteht man eine Ektrophorese in einem Agarosegel. Bei diesem Versuch wurden zunächst intakte Bakterienzellen aus der Kolonie gelöst und mit Cracking-Puffer vorbereitet – dieser „bricht“ die Zellen auf. Nach Einbringen in das Agarosegel werden diese „gecrackten“Zellen unter elektrische Spannung gesetzt. Im Ergebnis sieht man, dass das Plasmid, welches das lacZ-Gen enthielt, nicht mehr vorhanden ist.
An diesen anstrengenden Arbeitstagen, die immer von 09:00 Uhr bis 17:00 Uhr dauerten, wurden wir jedoch von den hauseigenen Foodtrucks mit wechselnden Gerichten aus Regionen wie Russland oder dem Irak verpflegt. Zwischen Pelmenis und Bakterienkulturen war es eine sehr angenehme Woche, welche schneller verging als ursprünglich gedacht. Und dabei trotzdem erstaunlich viel Wissen, bleibende Eindrücke und auch bestehende Freundschaften bereithielt.
Nick B., 12c